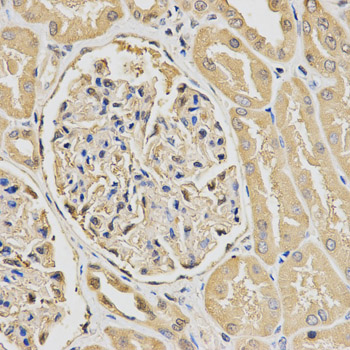
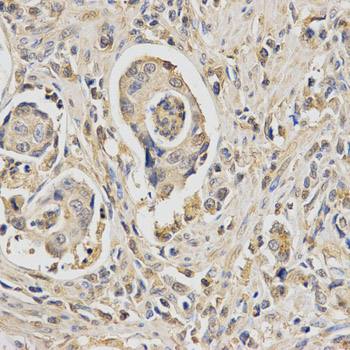

For quotations, please use our online quotation form, and you may also contact us by
service@kendallscientific.com
+1-888.733.6849 (Toll-free)
+1-617.299.7367 (Int’l))
+1-888.733.6849
Our customer service representatives are available 24 hours, Monday through Friday to assist you.| Reactivity | Human Mouse Rat |
| Tested applications | WB IHC IF |
| Recommended Dilution | WB 1:500 - 1:2000 IHC 1:50 - 1:200 IF 1:50 - 1:200 |
| Calculated MW | 31kDa |
| Observed MW | Refer to Figures |
| Immunogen | Recombinant protein of human HUS1 |
| Storage Buffer | Store at -20℃. Avoid freeze / thaw cycles. Buffer: PBS with 0.02% sodium azide, 50% glycerol, pH7.3. |
| Concentration | e |
| Synonym | hHUS1; |

Western blot analysis of extracts of various cell lines, using HUS1 antibody.
Immunohistochemistry of paraffin-embedded human kidney using HUS1 antibody at dilution of 1:200 (x400 lens).
Immunohistochemistry of paraffin-embedded human stomach cancer using HUS1 antibody at dilution of 1:200 (x400 lens).

Immunofluorescence analysis of U20S cell using HUS1 antibody. Blue: DAPI for nuclear staining.

Immunofluorescence analysis of U2OS cell using HUS1 antibody. Blue: DAPI for nuclear staining. DNA damage by a UV-A laser.
The protein encoded by this gene is a component of an evolutionarily conserved, genotoxin-activated checkpoint complex that is involved in the cell cycle arrest in response to DNA damage. This protein forms a heterotrimeric complex with checkpoint proteins RAD9 and RAD1. In response to DNA damage, the trimeric complex interacts with another protein complex consisting of checkpoint protein RAD17 and four small subunits of the replication factor C (RFC), which loads the combined complex onto the chromatin. The DNA damage induced chromatin binding has been shown to depend on the activation of the checkpoint kinase ATM, and is thought to be an early checkpoint signaling event. Alternative splicing results in multiple transcript variants.
N/A